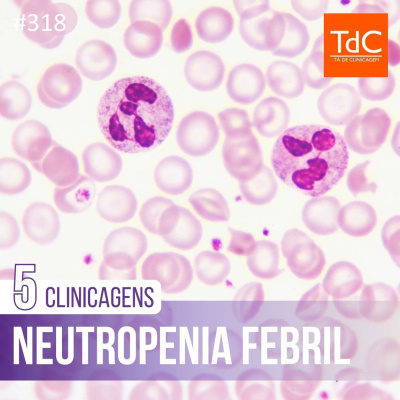
Ta de Clinicagem

Ta de Clinicagem
TdC 318: Neutropenia febril - 5 Clinicagens
- Autor: Vários
- Narrador: Vários
- Editora: Podcast
- Duração: 0:45:52
- Mais informações
Informações:
Sinopse
Iaaaago Jorge convida Raphael Barreto e Lucas Brandão para discutir sobre neutropenia febril, em 5 clinicagens:1. Neutropenia febril é emergência oncológica2. Como escolher o antibiótico?3. Quando escalonar o antibiótico?4. Quando suspender o antibiótico?5. Quando prescrever filgrastim?Referências:1. Klastersky J, de Naurois J, Rolston K, et al. Management of febrile neutropaenia: ESMO Clinical Practice Guidelines. Ann Oncol. 2016;27(suppl 5):v111-v118. doi:10.1093/annonc/mdw3252. Taplitz RA, Kennedy EB, Bow EJ, et al. Outpatient Management of Fever and Neutropenia in Adults Treated for Malignancy: American Society of Clinical Oncology and Infectious Diseases Society of America Clinical Practice Guideline Update. J Clin Oncol. 2018;36(14):1443-1453. doi:10.1200/JCO.2017.77.62113. Zhang H, Wu Y, Lin Z, et al. Naproxen for the treatment of neoplastic fever: A PRISMA-compliant systematic review and meta-analysis. Medicine (Baltimore). 2019;98(22):e15840. doi:10.1097/MD.00000000000158404. Zheng B, Huang Z, Huang